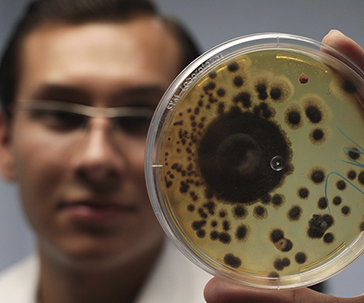
feria-ug-ugto-

As part of the pairing of Guanajuato University (UG) with the Montreal Symphony Orchestra, it will give a master class to the Guanajuato High School Symphony Orchestra (OSENMSG).
As part of the pairing of Guanajuato University (UG) with the Montreal Symphony Orchestra, it will give a master class to the Guanajuato High School Symphony Orchestra (OSENMSG).
 For three days, elementary school students from communities in Guanajuato learned about astronomy, mathematics, biology and metallurgy, among other disciplines, as part of the XVII Workshop on Sciences for elementary children, organized by Dr. Héctor Bravo Alfaro, a research professor at the University of Guanajuato (UG) and Dr. Johan Horebeek, of the Center for Research in Mathematics (CIMAT).
For three days, elementary school students from communities in Guanajuato learned about astronomy, mathematics, biology and metallurgy, among other disciplines, as part of the XVII Workshop on Sciences for elementary children, organized by Dr. Héctor Bravo Alfaro, a research professor at the University of Guanajuato (UG) and Dr. Johan Horebeek, of the Center for Research in Mathematics (CIMAT).
 As part of the development of one of the substantive functions of the UG, 19 projects from the different high schools (ENMS) were approved within the framework of the Call for Research in the High School College (CNMS) 2019–2020.
As part of the development of one of the substantive functions of the UG, 19 projects from the different high schools (ENMS) were approved within the framework of the Call for Research in the High School College (CNMS) 2019–2020.
 Students from the Engineering Division of the University of Guanajuato (UG) organized the ROB-COM competition to strengthen their academic growth by prototyping mobile robotics.
Students from the Engineering Division of the University of Guanajuato (UG) organized the ROB-COM competition to strengthen their academic growth by prototyping mobile robotics.
 40 students from the University of Guanajuato (UG) were recognized at the EGEL (General Examination of Graduate Egress) CENEVAL for the Performance of Excellence Award ceremony that was held at the Telmex Auditorium, in Zapopan, Jalisco. The award of recognitions had the University of Guadalajara as the host institution.
40 students from the University of Guanajuato (UG) were recognized at the EGEL (General Examination of Graduate Egress) CENEVAL for the Performance of Excellence Award ceremony that was held at the Telmex Auditorium, in Zapopan, Jalisco. The award of recognitions had the University of Guadalajara as the host institution.
 The "Bellísima María Patrona de Vizcaya", a representative work of new-Spanish baroque art, will be part of the collection that can be seen in the Museum of the University of Guanajuato (MUG).
The "Bellísima María Patrona de Vizcaya", a representative work of new-Spanish baroque art, will be part of the collection that can be seen in the Museum of the University of Guanajuato (MUG).
 With the development of the educational platform LUDOVERSO students from the Engineering Division of the Irapuato-Salamanca Campus of the University of Guanajuato (UG) took the first place in the LinceHack 2019.
With the development of the educational platform LUDOVERSO students from the Engineering Division of the Irapuato-Salamanca Campus of the University of Guanajuato (UG) took the first place in the LinceHack 2019.
 The sixth eUGreka: Your connection with science festival was held, an event that aims to bring children closer to science and technology through workshops offered by university students, who show the results of the knowledge generated in the laboratories of the house of studies.
The sixth eUGreka: Your connection with science festival was held, an event that aims to bring children closer to science and technology through workshops offered by university students, who show the results of the knowledge generated in the laboratories of the house of studies.
 Four teams of high school students (ENMS) from the University of Guanajuato (UG) obtained their pass to the national stage of the 2019 WER Robotics Tournament, after their participation in the regional stage that took place in the city of León.
Four teams of high school students (ENMS) from the University of Guanajuato (UG) obtained their pass to the national stage of the 2019 WER Robotics Tournament, after their participation in the regional stage that took place in the city of León.
 For his outstanding contributions in the field of physics, especially in the applications of supergravity in quantum cosmology, the Universidad Juárez Autónoma of Tabasco distinguished Dr. Octavio José Obregón Díaz, professor emeritus of the University of Guanajuato (UG) by dictating the extraordinary masterclass "Roberto Herrera Hernández" within the framework of the XXIX Forum of Physics.
For his outstanding contributions in the field of physics, especially in the applications of supergravity in quantum cosmology, the Universidad Juárez Autónoma of Tabasco distinguished Dr. Octavio José Obregón Díaz, professor emeritus of the University of Guanajuato (UG) by dictating the extraordinary masterclass "Roberto Herrera Hernández" within the framework of the XXIX Forum of Physics.

 Students from the University of Guanajuato (UG) won four silver medals and one bronze medal in the Ibero-American Inter-University Competition in Mathematics. This competition was held from September 19 to 24 at the Centre for Research in Mathematics (CIMAT).
Students from the University of Guanajuato (UG) won four silver medals and one bronze medal in the Ibero-American Inter-University Competition in Mathematics. This competition was held from September 19 to 24 at the Centre for Research in Mathematics (CIMAT).
The University of Guanajuato will show the potential it has to serve the industrial sector at the Hannover Fair 2019, an event that will be held in the city of León from October 9 to 11.
The University of Guanajuato will show the potential it has to serve the industrial sector at the Hannover Fair 2019, an event that will be held in the city of León from October 9 to 11.

 Students of the Regional Equity Program of the Celaya-Salvatierra Campus presented the work projects with which they seek to impact the development of families and support their communities of origin.
Students of the Regional Equity Program of the Celaya-Salvatierra Campus presented the work projects with which they seek to impact the development of families and support their communities of origin.
 The Division of Life Sciences of the University of Guanajuato (UG) launched the Small Species Clinic to provide medical care to pets, dogs and cats primarily.
The Division of Life Sciences of the University of Guanajuato (UG) launched the Small Species Clinic to provide medical care to pets, dogs and cats primarily.
 For two years, the Division of Natural and Exact Sciences (DCNE) has opened its doors to high school students in Guanajuato, who have had the opportunity to participate in projects focused on protecting the environment by applying their Chemistry, while strengthening ties with students at the top level.
For two years, the Division of Natural and Exact Sciences (DCNE) has opened its doors to high school students in Guanajuato, who have had the opportunity to participate in projects focused on protecting the environment by applying their Chemistry, while strengthening ties with students at the top level.

